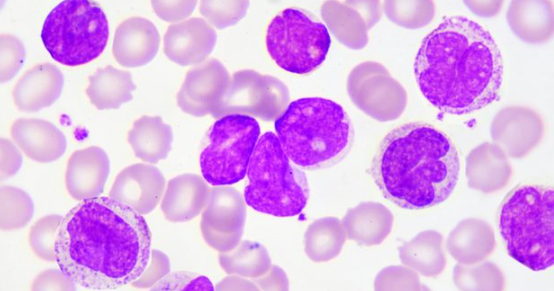

干扰素是在靶向药广泛用于临床时治疗慢粒白血病的“主力军”。那么,现在临床中还会用干扰素治疗慢粒白血病吗?首先,我们先了解干扰素是什么?干扰素是一种我们体内存在的自然物质,用来抵抗感染。而用于治疗慢粒白血病慢性期的药物,是一种人造的干扰素,叫做干扰素α,是格列卫等靶向药出现之前,最好的药物。
干扰素的作用机制:干扰素α阻止白血病细胞大幅增长。它还可以帮助身体的免疫系统发挥作用杀死白血病细胞。有一些病人认为干扰素治疗反应很好,但前提是这个患者的费城染色体分子学测试结果为阴性。但需要大家注意的是,干扰素治疗也是一种有毒性的治疗方法,有些副作用很明显,比如会引起高热,严重的身体疼痛,一些类似流感的症状,同时,一旦慢粒白血病病情恶化,干扰素也会逝去效力。
现在慢粒患者还在用干扰素吗?截至目前,很少有患者会使用干扰素治疗了,都是以格列卫为代表的酪氨酸激酶抑制剂为主,符合条件的可以进行骨髓移植,或者是配合中医中药辨证治疗,以促进融合基因尽快转阴,达到完全缓解的状态!不过,如果病人酪氨酸激酶和骨髓移植都行不通,病人可能需要干扰素类控制病情!